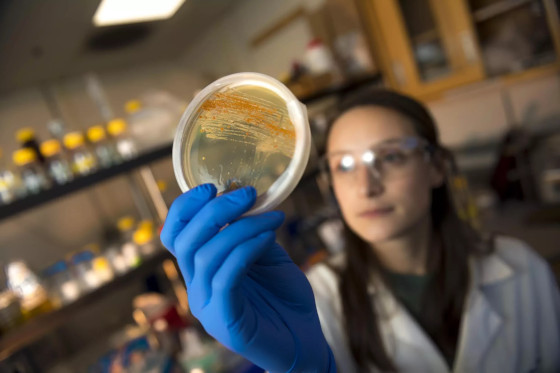

Descoperire în adâncurile mării: Molecule ce pot fi folosite într-un tratament revoluționar împotriva cancerului
Sunt ascunse în microbii sedimentelor, într-o bacterie care trăieşte în simbioză cu un melc de mare sau ascunse în secreţiile unui burete: moleculele care vor oferi un viitor tratament revoluţionar împotriva cancerului sau un nou antibiotic puternic sunt căutate în adâncurile mării de către oameni de ştiinţă, potrivit TV5 MONDE.
 Constrânși de bugete restrânse și cu puțin sprijin din partea marilor laboratoare, oamenii de știință sunt adesea nevoiți să se alăture altor expediții și să facă eforturi de imaginație pentru a-și recupera eșantioanele, uneori doar un tub de noroi.
Constrânși de bugete restrânse și cu puțin sprijin din partea marilor laboratoare, oamenii de știință sunt adesea nevoiți să se alăture altor expediții și să facă eforturi de imaginație pentru a-și recupera eșantioanele, uneori doar un tub de noroi.
Decenii între descoperirea și utilizarea unei molecule
Odată ce o moleculă a fost descoperită și s-a dovedit a fi benefică, de exemplu în tratamentul bolii Alzheimer sau al epilepsiei, este nevoie de mai mult de un deceniu și de sute de milioane de dolari pentru a o transforma într-un medicament.
Această explorare inovatoare, dar încă modestă, se află în centrul atenției, pe fondul negocierilor pentru un tratat crucial al ONU privind marea liberă. Cea mai recentă rundă de negocieri urmărește să ajungă la un acord privind zonele marine protejate.
Statele îşi dispută împărţirea beneficiilor derivate din resursele genetice marine, în special cele utilizate în medicamente, bioplasticele sau aditivii alimentari, a explicat Daniel Kachelriess, coresponsabil în negocierile pentru High Seas Alliance, o coaliţie de ONG-uri.
Cu toate acestea, doar un număr mic de produse derivate din resurse genetice marine îşi găsesc drumul spre piaţă. Doar şapte s-au înregistrat în 2019, menţionează Daniel Kachelriess.
Taxele potenţiale de licenţă sunt estimate între 10 şi 30 de milioane de dolari pe an. Probabil că mai sunt multe de descoperit în diversitatea biologică fenomenală a oceanelor.
În căutarea moleculelor marine
„Cu cât căutăm mai mult, cu atât găsim mai multe”, spune Marcel Jaspars de la Universitatea Aberdeen din Scoția.
De la descoperirea de către Alexander Fleming, în 1928, a unei specii de mucegaiuri care omoară bacteriile, penicilina, cercetătorii au găsit molecule vindecătoare în plante, animale, insecte și microbi de pe uscat.
„Marea majoritate a antibioticelor și a medicamentelor anticancerigene provin din surse naturale”, spune William Fenical, profesor la Institutul Scripps de Oceanografie din California.
Când acest pionier în vârstă de 81 de ani, aflat încă la conducerea unui laborator, a început să cerceteze moleculele marine în 1973, totul era privit cu scepticism.
Medicamente anticancerigene ascunse pe fundul oceanului?
Dar, în anii 1980, el şi colegii săi au descoperit un coral moale în Bahamas care producea o moleculă antiinflamatoare şi care a fost introdusă în produsele cosmetice Estée Lauder.
Cantităţile necesare i-au determinat în cele din urmă pe cercetători să se concentreze asupra microorganismelor. În prezent, cercetătorii colectează sedimente și cultivă microbii în laborator.
Tot în Bahamas, în 1991, cercetătorii au identificat o bacterie necunoscută, Salinispora. Astăzi, aceasta a condus la două medicamente anticancer, aflate acum în fazele finale ale testelor clinice.
17 medicamente de origine marină pe piață
Acest lung parcurs nu este o surpriză pentru Carmen Cuevas Marchante, şef de cercetare la PharmaMar, o companie spaniolă de biotehnologie.
Acest lung parcurs nu este o surpriză pentru Carmen Cuevas Marchante, şef de cercetare la PharmaMar, o companie spaniolă de biotehnologie.
În total, 17 medicamente de origine marină au fost autorizate pentru a trata afecţiuni umane din 1969, iar aproximativ 40 dintre ele se află în diferite stadii de studii clinice în întreaga lume, potrivit site-ului Marine Drug Pipeline.
Cele mai multe dintre aceste medicamente tratează cancerul, dar există și un antiviral pentru herpes provenit de la un burete de mare și un analgezic provenit de la un melc.
Experții spun că acest număr mic se datorează în parte costului uriaș al studiilor – uneori de peste 1 miliard de dolari – care favorizează dezvoltarea unor medicamente mai scumpe.
Există totuşi numeroase cercetări, de la malarie la tuberculoză, a afirmat Alejandro Mayer, profesor de farmacologie la Universitatea Midwestern.
Molecula pentru următorul antibiotic sau a viitorului tratament împotriva HIV aşteaptă poate îngropată într-o creatură pe fundul mării sau ascunsă cu înţelepciune sub carena unei ambarcaţiuni. Dacă nu cumva este deja în posesia noastră, în imensele biblioteci de molecule care urmează să fie testate.
Citiți și:
10 antibiotice naturale: aspecte despre care companiile farmaceutice preferă să nu vorbească
Apa de ocean, un substitut natural al sângelui?
yogaesoteric
31 martie 2023
Also available in:

